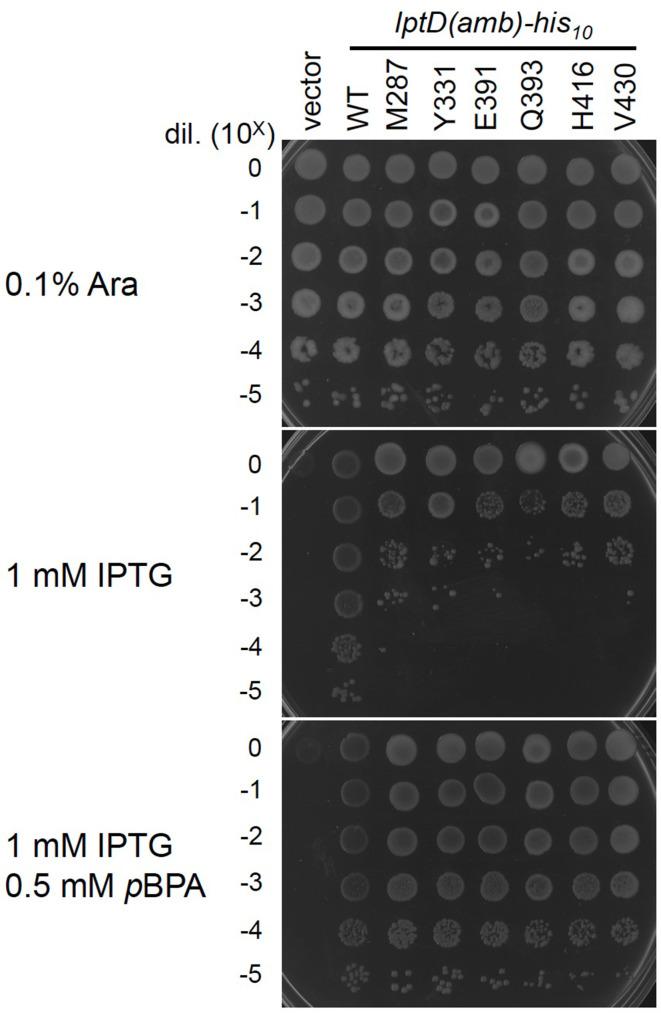
https://cdn.ncbi.nlm.nih.gov/pmc/blobs/a942/8423444/522451c411ee/elife-70541-fig2-figsupp2.jpg

BepA 的边缘链与β-桶组装机器上不成熟的 LptD 相互作用,将其引导至成环和非成环途径。
Edge-strand of BepA interacts with immature LptD on the β-barrel assembly machine to direct it to on- and off-pathways.
机构信息
Institute for Frontier Life and Medical Sciences, Kyoto University, Kyoto, Japan.
出版信息
Elife. 2021 Aug 31;10:e70541. doi: 10.7554/eLife.70541.
The outer membrane (OM) of Gram-negative bacteria functions as a selective permeability barrier. periplasmic Zn-metallopeptidase BepA contributes to the maintenance of OM integrity through its involvement in the biogenesis and degradation of LptD, a β-barrel protein component of the lipopolysaccharide translocon. BepA either promotes the maturation of LptD when it is on the normal assembly pathway (on-pathway) or degrades it when its assembly is compromised (off-pathway). BepA performs these functions probably on the β-barrel assembly machinery (BAM) complex. However, how BepA recognizes and directs an immature LptD to different pathways remains unclear. Here, we explored the interactions among BepA, LptD, and the BAM complex. We found that the interaction of the BepA edge-strand located adjacent to the active site with LptD was crucial not only for proteolysis but also, unexpectedly, for assembly promotion of LptD. Site-directed crosslinking analyses indicated that the unstructured N-terminal half of the β-barrel-forming domain of an immature LptD contacts with the BepA edge-strand. Furthermore, the C-terminal region of the β-barrel-forming domain of the BepA-bound LptD intermediate interacted with a 'seam' strand of BamA, suggesting that BepA recognized LptD assembling on the BAM complex. Our findings provide important insights into the functional mechanism of BepA.
革兰氏阴性细菌的外膜(OM)作为一种选择性渗透屏障发挥作用。周质锌金属肽酶 BepA 通过参与 LPS 转位器的β-桶蛋白成分 LptD 的生物发生和降解,有助于维持 OM 完整性。BepA 要么在正常组装途径(途径)上促进 LptD 的成熟,要么在其组装受到损害时降解它(途径)。BepA 可能在β-桶组装机制(BAM)复合物上执行这些功能。然而,BepA 如何识别和指导未成熟的 LptD 进入不同的途径仍不清楚。在这里,我们探讨了 BepA、LptD 和 BAM 复合物之间的相互作用。我们发现,位于活性位点附近的 BepA 边缘链与 LptD 的相互作用不仅对蛋白水解至关重要,而且出乎意料的是,对 LptD 的组装促进也至关重要。定点交联分析表明,未成熟 LptD 的β-桶形成域的无规卷曲 N 端半部分与 BepA 边缘链接触。此外,BepA 结合的 LptD 中间产物的β-桶形成域的 C 端区域与 BamA 的“接缝”链相互作用,表明 BepA 识别在 BAM 复合物上组装的 LptD。我们的发现为 BepA 的功能机制提供了重要的见解。